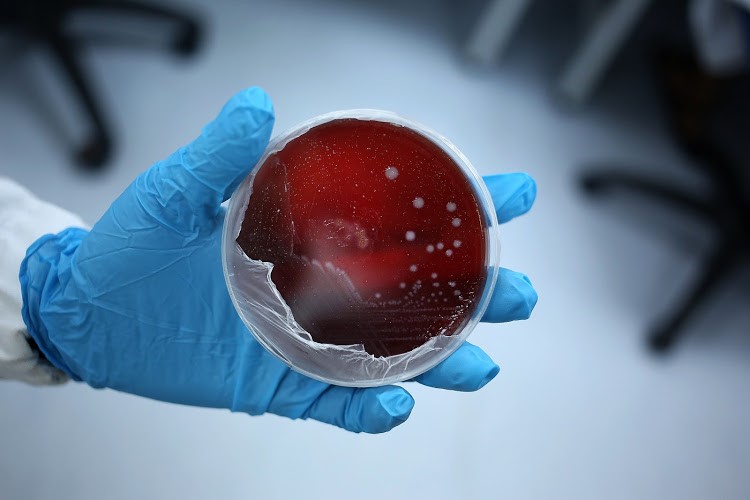

Identificação de perigos biológicos, químicos e físicos em alimentos de origem vegetal
O post de hoje é uma entrevista com o Dr. Rafael Ribeiro Gonçalves Barrocas, auditor fiscal federal agropecuário do MAPA há 18 anos. Ele é


O post de hoje é uma entrevista com o Dr. Rafael Ribeiro Gonçalves Barrocas, auditor fiscal federal agropecuário do MAPA há 18 anos. Ele é
.jpg)
Com uma trajetória profissional rica e diversificada, nosso entrevistado de hoje é Geidemar Oliveira. Ele vem consolidando ao longo dos anos conhecimento em várias áreas

Diversos surtos de Salmonella, envolvendo mais de 500 pessoas, ocorreram nos últimos dois anos na Europa, evidenciando novamente os riscos no consumo de brotos de

Neste artigo trago uma entrevista abordando tendências sobre microrganismos deteriorantes com minha querida amiga, a Profa. Dra. Karen Signori Pereira, da UFRJ. FSB – Além

O Simpósio Latino Americano em Segurança de Alimentos – IAFP Latino 2024 – foi realizado em Santos, entre os dias 11 e 14 de novembro

Está em investigação nos EUA um novo recall de alimentos por contaminação com Listeria monocytogenes. O recall está ativo desde 26 de julho de 2024

Hoje finalizamos os destaques do IX Encontro dos Profissionais da Garantia da Qualidade. Wilson Tamega Jr., da VISA de São Paulo, explicou em sua palestra,

Demorou, mas seguimos com os destaques do IX Encontro dos Profissionais da Garantia da Qualidade! No segundo dia de evento, tivemos uma apresentação incrível sobre

Retomando os pontos mais interessantes do IX Encontro dos Profissionais da Garantia da Qualidade! O evento contou com a participação de Roberto Melco – gerente

O IX Encontro dos Profissionais da Garantia da Qualidade teve, como um dos temas, “Colhendo resultados efetivos de um plano de monitoramento ambiental baseado em

O tema deste ano do IX Encontro dos Profissionais da Garantia da Qualidade foi “Encarando demandas Intensas”. E foi um evento super intenso! Com tanto
Novas espécies de Listeria estão sendo descritas! A Listeria pertence à família Listeriaceae, que possui somente 2 gêneros: Brochothrix e Listeria. Até 2010, o gênero

Um novo recall de fórmula infantil por risco de contaminação por Cronobacter sakazakii está em andamento, envolvendo mais de 20 países. Em 28/12/23 o FDA

No dia 01/11/2023 foi declarado encerrado o surto de E. coli 0157 em 11 creches canadenses, na província de Alberta, que envolveu 446 pessoas. Foram

O ITAL realizou um evento em Campinas/SP, no dia 23/08/23, para lançar sua nova publicação: Brasil Food Safety Trends 2030. Neste novo documento foram discutidas

O Conselho de Epidemiologistas Estaduais e Territoriais (CSTE), um grupo formado por especialistas dos Estados Unidos em colaboração com representantes do FDA e Associação de

Você já ouviu falar do Movimento dos Profissionais da Área de Cultura de Segurança de Alimentos? Nesta semana tive o prazer de entrevistar o querido

No dia 01 de março de 2023, acontecerá o 1º Simpósio Internacional Neogen Food Safety, no Centro de Convenções Rebouças, em São Paulo. Para quem

No dia 07/12 aconteceu o 1° Simpósio de Qualidade Seara, em São Paulo, onde foram discutidas tendências nacionais e globais de consumo de alimentos, proteínas,

Nesta semana o MAPA interceptou 49 toneladas de uvas-passas e evitou que muita gente tivesse um Natal com gosto de micotoxinas! Para entender melhor o

Você sabia que, nos Estados Unidos, a partir do dia 1° de janeiro de 2023 teremos o Big 9: Gergelim passará a ser considerado alergênico?

A demanda global por alimentos mais sustentáveis e a garantia à nutrição adequada tem gerado novos questionamentos, como a dúvida: Alimentos plant-based aumentam os riscos

Em julho de 2022, tive o prazer de participar do evento de lançamento do livro Segurança de Alimentos na Gastronomia, do Professor Eduardo C. Tondo,

Uma pesquisa internacional sobre a efetividade dos treinamentos em Cultura de Segurança de Alimentos mostrou resultados interessantes. Nessa amostra, foram ouvidos mais de 2 mil